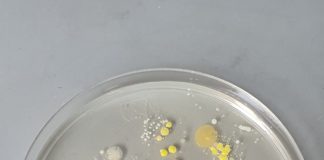
Mikrobiolog-i-ja
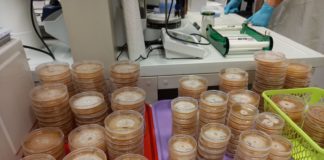
Šumski detektivi

Radionice Biolog-i-Ja 2024
Radionice za osnovne škole (5. - 8. razred)
Life-size Čovječe ne ljuti se
Čovječe ne ljuti se – svima poznata društvena igra, odlična je za opuštanje, igru, zabavu, a mi ćemo dodati i učenje. Za sve naše...
Dođi na blef i postani LabChef
Jeste li kada probali raviole od šećerne vune, voćni kavijar ili špagete od povrća? Ako niste, budite znanstvenici u kuhinji i spojite svoje kulinarske...
Kukci – sitni, ali bitni
Bez njih, svijet kakav poznajemo ne bi postojao. Koja je uloga kukaca (lat. Insecta) u raznolikosti života na Zemlji? Koje su njihove glavne karakteristike?...
Beskralježnjaci kao inspiracija u svijetu stripova i filma
Jeste li se ikada zapitali kako pod povećalom izgledaju životinje koje su poslužile kao inspiracija za brojne izmišljene likove u svijetu stripova i filma?...
Bioplet – dizajn s algama
Sve veća količina plastike značajno utječe na okoliš, bioraznolikost i ljudsko zdravlje. Među ekološki prihvatljivim materijalima koji mogu zamijeniti plastiku su alginati čija je...
Oh.BAD – crno nam se piše!
Tijekom ove radionice upoznajte zanimljivi svijet obada, kukaca koji svojom prisutnošću obogaćuju faunu Hrvatske. Znate li da su ženke obada u odraslom stadiju tijekom...
Skriveni život u žličici tla
U skladu s trenutačnim stanjem istraživanja u području, sve veća pažnja se posvećuje važnosti očuvanja zdravlja tla, njegove funkcionalnosti i bioraznolikosti. Uistinu, tlo je...
Mikrobiolog-i-ja
Bakterije su posvuda u našem okolišu. Štoviše, prisutne su i u našem tijelu te na površini naše kože gdje su u većini slučajeva jako...
Aquafun: Igraj, otkrij, uči!
Društvene igre pružaju mnoge edukativne prednosti, potičući razvoj kognitivnih, komunikacijskih i socijalnih vještina kod djece. Kroz igru, djeca razvijaju kreativnost, uče o disciplini, organizaciji...
Šumski detektivi
Cilj radionice “Šumski detektivi” je učenicima dati uvid u metode istraživanja biljnih patogena na primjeru fitopatogene gljive Ophiostoma novo-ulmi, uzročnika holandske bolesti brijesta te...
Gdje se skriva famozna vrpca?
Ona je molekula koja nosi uputu za specifični razvoj živih organizama, nalazi se u stanicama, a može biti duža od prosječne visine čovjeka. Ona...
Biološke pustolovine
Biti znanstvenik velika je pustolovina i izazov. Biologija je znanost koja se temelji na opažanju i opisivanju prirodnih pojava koje se ispituju pokusima, a...
Pronađi me ako možeš!
Životinje su tijekom evolucije razvile brojne prilagodbe koje im omogućavaju bolje preživljavanje, a jedna od njih je i mimikrija. Mimikrija je sposobnost životinja da...
Radionice za srednje škole
Carstvo izgubljenih lubanja
Radionica ima za cilj potaknuti učenike da razvijaju interes i poštovanje prema prirodi, istovremeno razvijajući kreativnost i praktične vještine. Učenici će se kroz interaktivni...
Lov na blago Odjela za biologiju
Treću godinu za redom pozivamo vas da se okušate u Lovu na blago, ove godine u nešto izmijenjenom formatu, ali i dalje uz puno...
Možemo li biti par? – molekularna detekcija gena za spolno razmnožavanje
Cilj radionice “ Možemo li biti par? - molekularna detekcija gena za spolno razmnožavanje” je učenicima dati uvid u metode istraživanja biljnih patogena na...
Oh.BAD – crno nam se piše!
Tijekom ove radionice upoznajte zanimljivi svijet obada, kukaca koji svojom prisutnošću obogaćuju faunu Hrvatske. Znate li da su ženke obada u odraslom stadiju tijekom...